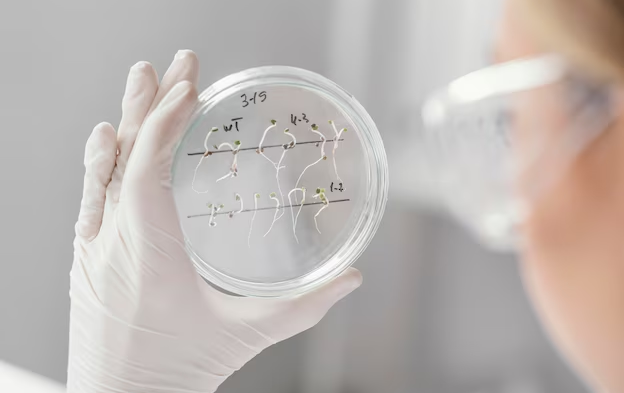

La estética regenerativa ha revolucionado el mundo de la medicina estética, y las células madre han tomado un papel protagónico en este cambio.
Innovadora estética regenerativa: El futuro de la belleza con células madre
estética regenerativa
estética regenerativa Hoy en día, las células madre se utilizan no solo para mejorar la apariencia física, sino también para regenerar y rejuvenecer los tejidos, haciendo que los tratamientos sean más efectivos y duraderos. A continuación, exploraremos cómo la estética regenerativa, específicamente a través del uso de células madre, está transformando el concepto de belleza.
¿Qué son las células madre y cómo funcionan?
Las células madre son células especiales con la capacidad única de convertirse en diferentes tipos de células del cuerpo y regenerar tejidos. Esto significa que tienen el potencial de reparar y renovar diversas partes del cuerpo que han sufrido daño o desgaste con el tiempo. Existen varios tipos de células madre, pero las más comunes en tratamientos estéticos son las que se extraen de la grasa corporal del propio paciente. Este proceso, conocido como “liposucción asistida por células madre”, minimiza el riesgo de rechazo, ya que se utilizan las propias células del cuerpo.
Una vez extraídas, estas células madre se procesan en un laboratorio para concentrarlas, y luego se inyectan en áreas específicas del cuerpo donde se busca el rejuvenecimiento. Los efectos de las células madre no son superficiales, ya que tienen la capacidad de promover la producción de colágeno, elastina y otros componentes esenciales para mantener la piel sana y firme.
Aplicaciones de las células madre en estética
La estética regenerativa ofrece una gama de tratamientos que permiten regenerar y restaurar los tejidos de manera natural. Algunas de las aplicaciones más comunes son:
1. Rejuvenecimiento facial
Uno de los usos más populares de las células madre en estética es el rejuvenecimiento facial. Con el paso del tiempo, la piel pierde elasticidad y firmeza, lo que lleva a la aparición de arrugas, líneas finas y flacidez. Las terapias con células madre buscan revertir estos efectos estimulando la regeneración celular desde el interior. Al inyectar células madre en áreas específicas del rostro, se promueve la producción de colágeno, mejorando la textura, el tono y la elasticidad de la piel.
Este tratamiento es especialmente efectivo para reducir la apariencia de arrugas profundas y líneas finas alrededor de los ojos, la boca y el cuello. A diferencia de los tratamientos tradicionales, que solo ofrecen resultados temporales, el rejuvenecimiento facial con células madre ofrece una mejora más sostenida en el tiempo.
2. Regeneración capilar
Otro de los campos donde las células madre han demostrado ser altamente eficaces es en la regeneración capilar. La pérdida de cabello es un problema común que afecta tanto a hombres como a mujeres, y puede estar relacionada con la genética, el envejecimiento o factores ambientales. Las células madre tienen la capacidad de reactivar los folículos capilares, promoviendo el crecimiento de cabello nuevo y saludable.
Este tipo de tratamiento se realiza mediante la inyección de células madre en el cuero cabelludo, donde se busca estimular los folículos inactivos para que vuelvan a producir cabello. Con el tiempo, los pacientes notan una melena más densa y fuerte, y el cabello tiende a ser más resistente a los daños futuros.
3. Tratamiento de cicatrices y manchas
Las células madre también son altamente efectivas en el tratamiento de cicatrices y manchas en la piel. Las cicatrices, ya sean causadas por heridas, quemaduras o acné, pueden ser difíciles de tratar con métodos convencionales. Sin embargo, las terapias con células madre permiten regenerar el tejido dañado, promoviendo una piel más uniforme y tersa.
El tratamiento de manchas y cicatrices con células madre funciona de manera similar al rejuvenecimiento facial. Las células madre se inyectan en las áreas afectadas para regenerar la piel desde el interior, reduciendo la apariencia de las imperfecciones y mejorando el tono general de la piel.
Ventajas de la estética regenerativa con células madre

El tratamiento con células madre para la piel es fundamental porque promueve la regeneración celular, mejorando la elasticidad, firmeza y apariencia de la piel de manera natural y prolongada.
Una de las principales ventajas de los tratamientos con células madre es su capacidad para ofrecer resultados naturales y duraderos. A diferencia de otros procedimientos estéticos que pueden alterar la apariencia de manera artificial, las células madre trabajan con los propios procesos naturales del cuerpo, promoviendo una mejora gradual pero efectiva.
Además, al utilizar células del propio paciente, se reduce significativamente el riesgo de reacciones alérgicas o complicaciones. Este enfoque personalizado y biocompatible es ideal para aquellos que buscan mejorar su apariencia sin someterse a tratamientos invasivos o agresivos.
Otra ventaja importante es la versatilidad de las terapias con células madre. Pueden ser utilizadas en una amplia variedad de tratamientos estéticos, desde el rejuvenecimiento facial hasta la regeneración capilar, cicatrices y manchas, lo que las convierte en una herramienta poderosa en la medicina estética
El campo de la medicina estética sigue evolucionando, y las células madre se encuentran en la vanguardia de este cambio. A medida que la ciencia avanza, es probable que veamos aún más aplicaciones de las células madre en tratamientos estéticos, no solo para combatir los signos visibles del envejecimiento, sino también para mejorar la salud y el bienestar general de la piel.
Los expertos predicen que los tratamientos con células madre serán cada vez más accesibles, y su popularidad seguirá creciendo en los próximos años. Con su capacidad para regenerar y rejuvenecer los tejidos, las células madre representan el futuro de la belleza y la estética.

